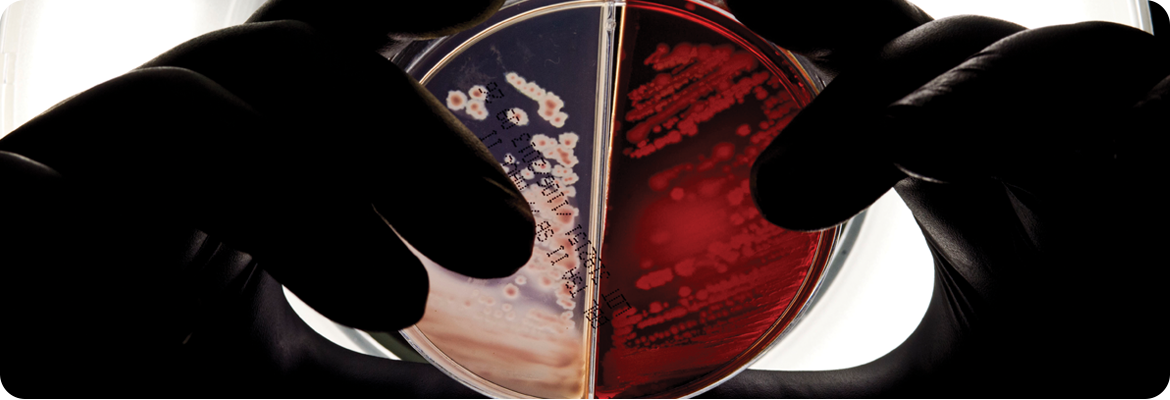
Gloved hands hold up a petri dish divided into two sections, one containing a red agar medium with bacterial growth and the other a lighter medium with visible colonies, illuminated from behind.

Foundations and Global Growth: 1947 - 1968

Dr. Henry Foster founds Charles River Breeding Laboratories in a second floor loft overlooking the Charles River in Boston with the goal of providing researchers with a new standard of high-quality.

1952
The Company’s headquarters is relocated to 60 acres of farmland in Wilmington, Massachusetts and begins commercial production of pathogen-free rodents by utilizing the industry’s first barrier-type building for rat production.
1956
The first Caesarean-Originated, Barrier Sustained (COBS®) animals are introduced, which become the new industry standard for animal production.


1957
Understanding the importance of providing the highest-quality models, we adopt flexible film isolator technology to rear gnotobiotic and germ-free animals.
1966
We become an international company with the opening of a new production facility in France.


1968
On July 9, 1968, the Company went public for the first time on NASDAQ, offering 160,000 shares at $21 per share.
Advances and Key Partnerships: 1969 - 1988

Charles River’s Astromice® became the first earth animals to be exposed to moon dust prior to the release from quarantine of Apollo 11 astronauts Neil Armstrong, Buzz Aldrin, and Michael Collins.

1974
Routine serology testing for murine viruses is initiated and performed on all our colonies to ensure the colonies are free of unwanted microbes.
1981
We institute the first commercial comprehensive genetic monitoring program, including embryology, custom breeding, and genetic testing.


1984
Virus Antibody Free (VAF/Plus®) animals are introduced, setting the standard for high-quality research models. This term refers to a form of specific pathogen-free status and has become an acronym in its own right for a specific quality of animal.
Bausch & Lomb acquires Charles River; Henry and Jim Foster continue to run company.
1988
The Company enters the field of transgenic services with OncoMouse, genetically modified to contain a specific cancer gene (a gene for breast cancer), and the first transgenic mammal to ever be patented.

Leadership and Preclinical Expansion: 1991 - 1999

Jim Foster is named President and Chief Operating Officer in 1991, and President and Chief Executive Officer in 1992.

1994
Endosafe, Inc., a manufacturer of Limulus Amebocyte Lysate products and provider of in vitro endotoxin testing solutions, is acquired.
1997
Our Insourcing Solutions® team begins providing staffing, training, consulting, and other animal facility support services to help clients optimize their discovery and development programs and run their facilities more efficiently.


1998
The Company acquires Tektagen, a contract testing company that provides biosafety and analytical testing services.
1999
Jim Foster and the Charles River management team buys the Company back from Bausch & Lomb.
The Company enters into the preclinical safety assessment business, acquiring Sierra Biomedical, a company specializing in large model toxicology testing.

Public Re-entry and Research Growth: 2000 - 2009

The Company goes public for a second time on the New York Stock Exchange (NYSE: CRL).

2001
We acquire five preclinical safety sites in the U.S., and over the next three years, three more sites in North America and Europe including Inveresk, its largest acquisition ever, establishing the Company as a market leader in toxicology, pathology, and safety pharmacology.
2002
We launched the Humane Care Initiative, which is designed to raise awareness and provide employee training on the importance of animal welfare.
The Boston Globe names Charles River “Company of the Year.”


2005
Preconditioning Services are introduced, providing clients with animals that meet all of their specifications at time of delivery.
2009
With acquisitions in the U.S. and Finland, we add discovery services in oncology and neuroscience, thereby offering a range of studies aimed at evaluating compounds for efficacy.

Global Expansion and Safety Innovation: 2012 - 2017
Accugenix, the premier global provider of cGMP-compliant contract microbial identification testing, is acquired, strengthening its Endotoxin and Microbial Detection portfolio.

2013
The acquisition of Vital River, the premier provider of research models and associated services in China, establishes us as a provider of high-quality research models and services to this emerging market.
2014
Argenta and BioFocus are acquired, positioning us as a full service, early-stage contract research organization, with integrated in vitro and in vivo capabilities from target discovery through preclinical development.
ChanTest, a leading provider of cardiac risk assessment and ion channel screening, is acquired.


2015
Celsis International joins our Endotoxin and Microbial Detection lineup, providing rapid microbial detection to the pharmaceutical, consumer care, and dairy, beverage, and food industries.
We launch CRADL® (Charles River Accelerator and Development Lab), providing flexible, turnkey vivarium rental solutions.
2016
WIL Research is acquired to further enhance the Company’s ability to provide safety assessment and contract manufacturing services globally.
Blue Stream Laboratories is added to our portfolio, enhancing analytical capabilities and biologic and biosimilar development.
Agilux Laboratories is purchased, providing scientific proficiency to support research needs from target identification through preclinical development.


2017
Brains On-Line, a discovery services provider of novel therapeutics for the treatment of central nervous system (CNS) diseases, is acquired, establishing us as a single-source provider of discovery CNS services.
Leadership in Drug Development: 2018 - Present

KWS BioTest, a leading CRO specializing in in vitro and in vivo discovery testing is acquired, expanding the Company’s expertise in immunology.
MPI Research, a non-clinical CRO providing comprehensive testing services to biopharmaceutical and medical devices worldwide, is acquired, enhancing our position as a premier early-stage CRO.

2020
During the COVID-19 pandemic, we work on the discovery and development of every COVID vaccine approved for emergency use or fully approved.
The Company acquires HemaCare and Cellero, producers of human-derived cellular products critical for the cell therapy market.
2021
We acquire Cognate BioServices and Vigene Biosciences, entering into the contract development and manufacturing organization (CDMO) market.
The Company acquires Retrogenix®, strengthening its scientific expertise with the addition of Cell Microarray Technology and Off-Target Profiling for drug discovery.


2022
The company adds Explora BioLabs, a provider of full-service contract vivarium research services.
We are the first CDMO in North America to receive regulatory approval to commercially produce allogeneic cell therapy products for distribution in Europe.
2023
We introduce Endosafe® Trillium™, an animal-free recombinant cascade Reagent (rCR), and the latest addition to its bacterial endotoxin detection portfolio.
The Company introduces RightSourceSM, a novel, first of its kind insourcing solution serving biotech and biopharmaceutical companies with the panel of our proprietary assays they deem most necessary for their biologics manufacturing program to have in-house.
We complete the acquisition of SAMDI Tech, a leading provider of high-quality, label-free high -throughput screen (HTS) solutions for drug discovery research.


2024
The Company launches Alternative Methods Advancement Project (AMAP) to reduce reliance on animal testing.



